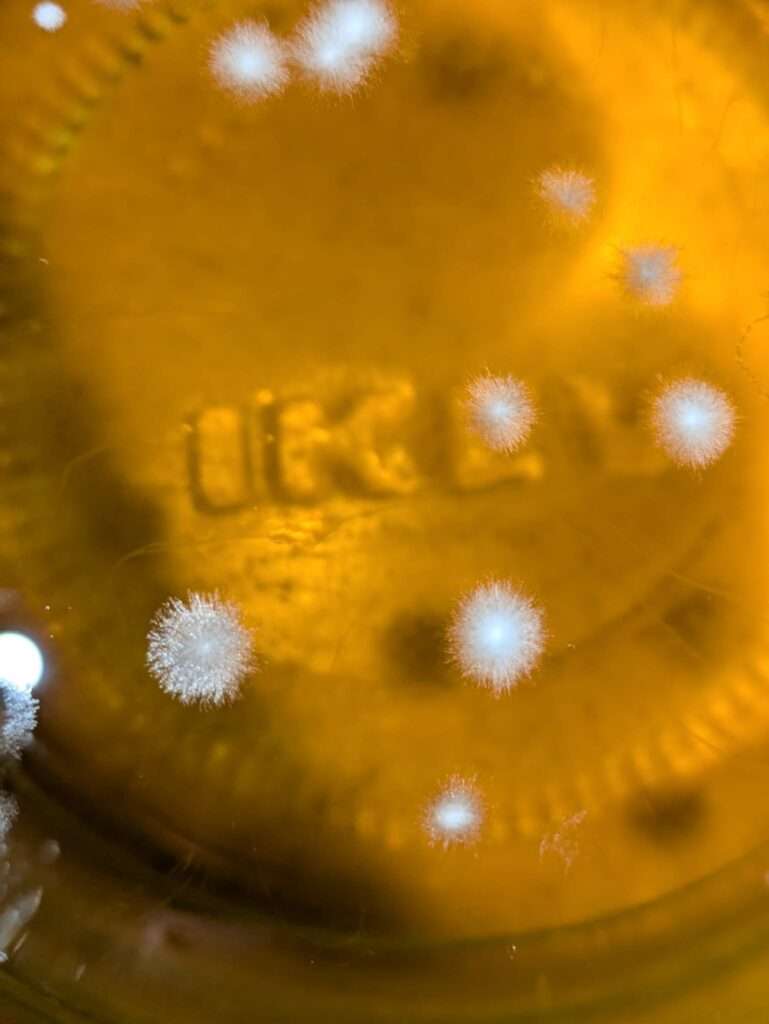
Schimmel Reinzucht
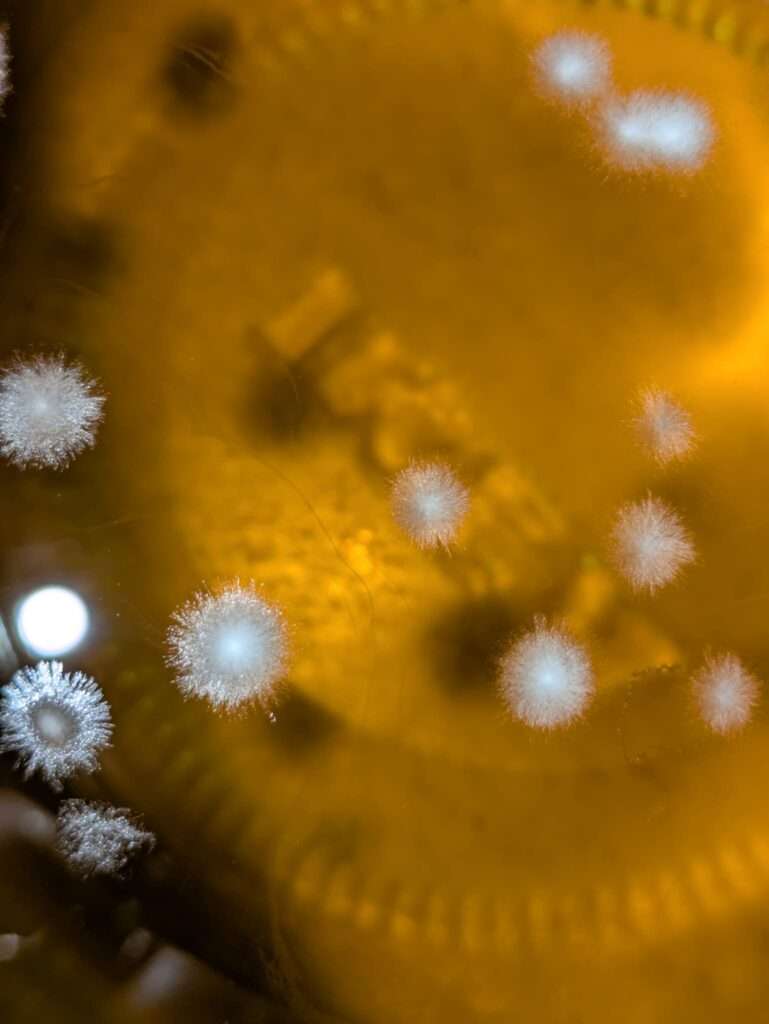
Schimmel Reinzucht

Reinzuchthefe Test: Warum flüssige Hefen versagen können
Reinzuchthefe-Tests können selbst bei optimalen Bedingungen überraschend scheitern. Mein Experiment mit vier verschiedenen flüssigen Reinzuchthefen sollte eigentlich perfekt verlaufen – saubere Gläser, weißer Traubensaft, normale Zimmertemperatur und bereits aktive Mikroorganismen. Doch während die Champagnerhefe nach 24 Stunden zuverlässig ansprang, entwickelte sich bei den anderen Ansätzen statt der erwünschten Gärung gefährlicher Schimmel. Warum selbst flüssige Hefen versagen können und was du aus meinen Fehlern lernen kannst, erfährst du in diesem ausführlichen Erfahrungsbericht.
Eigentlich hatte ich alles richtig gemacht. Vier verschiedene Reinzuchthefen, diesmal sogar als flüssige Varianten. Kein Trockenhefe-Start, keine Rehydrierungsphase. Die Mikroorganismen sollten bereits aktiv und bereit sein. Weißer Traubensaft, saubere Gläser, gleiche Bedingungen, normale Zimmertemperatur.
Und trotzdem ist der erste Versuch teilweise gescheitert.
Die Champagnerhefe legte nach gut 24 Stunden sichtbar los. Der Saft wurde trüber, kleine Bläschen stiegen auf, die Oberfläche begann sich zu schließen. Man hatte das Gefühl: Hier arbeitet etwas. Hier passiert Gärung.


Die anderen Ansätze wirkten zunächst völlig unauffällig. Klarer Saft, keine erkennbare Aktivität, optisch ruhig. Doch genau diese Ruhe wurde zum Problem. Denn während ich noch darauf wartete, dass sich etwas tut, begann sich auf der Oberfläche etwas anderes zu entwickeln: kleine, runde, weißliche Inseln. Erst unscheinbar, dann eindeutig. Schimmel.



Was auf den ersten Blick harmlos aussah, entwickelte sich innerhalb kurzer Zeit zu einem klaren Bild: kleine, runde, weiß-flaumige Inseln auf der Oberfläche. Kein Zweifel mehr – Schimmel.

Der erste Versuch war gescheitert.
Das Überraschende daran: Es waren flüssige Hefen. Eigentlich sollte man erwarten, dass sie schneller starten als Trockenhefen. Sie müssen nicht erst rehydrieren, nicht erst „aufwachen“. Und doch gab es offenbar eine Phase, in der sie noch nicht dominant genug waren.
Fermentation ist kein exklusiver Prozess. Traubensaft ist kein steriles Medium. Er enthält Zucker, Nährstoffe und anfangs auch Sauerstoff. Genau das ist nicht nur für Hefe attraktiv. In dem Moment, in dem die Hefe noch nicht ausreichend CO₂ produziert, bleibt die Oberfläche angreifbar. Und Luftkeime brauchen keine Einladung.
Die Champagnerhefe war schlicht schneller. Sie übernahm das Milieu rasch, produzierte CO₂ und schuf damit eine schützende Atmosphäre. Die langsameren Stämme hingegen ließen ein Zeitfenster offen – und dieses Zeitfenster hat gereicht.
Zimmertemperatur spielt dabei eine doppelte Rolle. Sie ist ideal für Gärung, aber eben auch ideal für andere Mikroorganismen. Ohne sterile Bedingungen entscheidet am Ende nicht nur die Qualität der Hefe, sondern ihre Geschwindigkeit und Konkurrenzfähigkeit.
Der erste Versuch hat damit weniger über „gute“ oder „schlechte“ Hefen ausgesagt, sondern viel mehr über Dynamik. Selbst flüssige Reinzuchthefen garantieren keinen sofortigen Vorsprung. Wenn sie sich nicht schnell genug durchsetzen, entstehen Lücken – und Lücken werden genutzt.
Beim zweiten Versuch wird deshalb nicht grundsätzlich alles verändert, sondern gezielt optimiert. Die Gefäße werden noch konsequenter vorbereitet, der Sauerstoffkontakt schneller reduziert und die Ansätze enger geführt. Entscheidend ist, dass die Hefe möglichst vom ersten Moment an die Oberhand gewinnt.
Ob der zweite Durchgang erfolgreicher wird?
Sehr wahrscheinlich. Nicht, weil plötzlich alles anders ist, sondern weil klar geworden ist, worauf es wirklich ankommt: Die Startphase entscheidet. Wer zuerst aktiv wird, bestimmt die Richtung.
Fermentation ist eben kein stiller Prozess – sondern ein Wettlauf im Kleinen.
Und genau deshalb bleibt es spannend.







